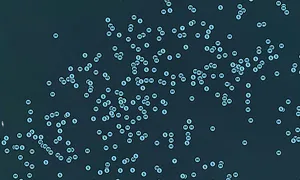

LE REVE, MMSI: 367685870
 United States
United States
Follow the journey
Images of LE REVE
Journey statistics
Preferred harbour type
2026
67% marina
natural harbour 33%
2025
44% marina
natural harbour 56%
2024
45% marina
natural harbour 55%
2023
29% marina
natural harbour 71%
2020
91% marina
natural harbour 9%
2019
80% marina
natural harbour 20%
2018
88% marina
natural harbour 12%